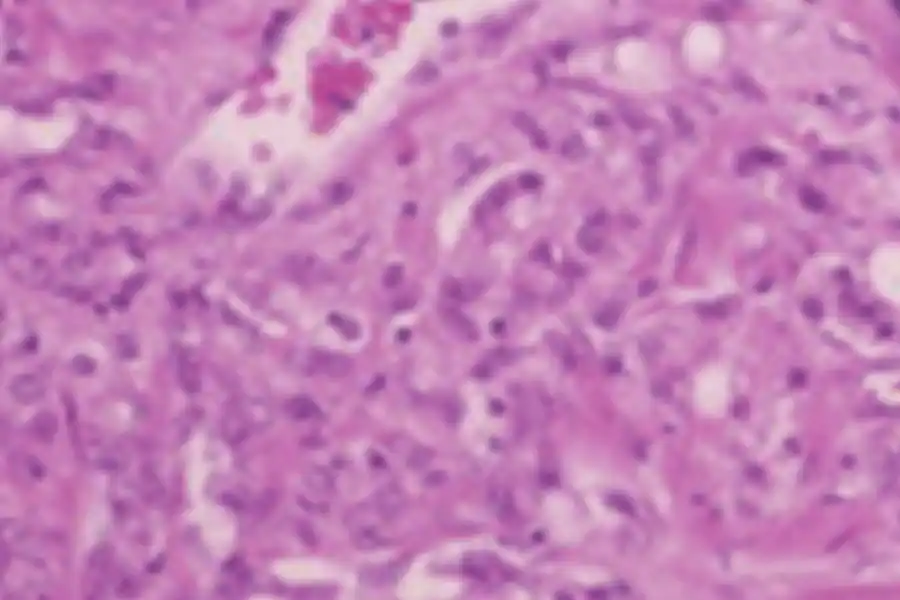
病理検査

病理検査部門の概要
患者様が病院に来院されると、適切な治療のために適切な診断が必要になります。「病理診断」は最終診断として大きな役割を果たしています。病理検査室では大きく分けて組織診断、細胞診断、病理解剖の3つを行っています。
■組織診断
◆生検組織診断
胃、大腸の内視鏡検査で病変部より小さな組織を採取し、その組織標本を作製し顕微鏡で診断します。
◆手術材料の診断
手術で切除した組織を標本にして顕微鏡でその病変の種類や進み具合を診断します。これをもとに手術後の治療が行われます。
◆術中迅速診断
手術中に切除範囲の決定や癌の転移の有無を調べる場合に行われます。手術中に採取された病変を凍結し、標本を作製、15分で病理診断が行われます。この診断結果をもとに手術方針が決定されます。
■標本の作製から診断まで
①ホルマリン固定
②切り出し:必要な部分を切り出す
③パラフィン包埋:パラフィンを浸透させ埋める
④薄切:薄く切る
⑤HE染色:色をつける
⑥顕微鏡でみて診断

■細胞診断
痰、尿、体腔液の中の細胞を集めたり、子宮の一部から細胞を擦り取って標本を作製しがん細胞を顕微鏡で調べます。また、乳腺や甲状腺のしこりは針で病変から吸引し、その細胞を診断します。

■病理解剖
不幸にしてなくなられた患者様を、ご遺族の承諾をもとに、ご遺体を解剖するのが病理解剖です。生前の診断が正しかったか、病気の進み具合、適切な治療がなされていたか、治療の効果はあったのか、死因は何かなどを検討します。 病理解剖が終わった後、病理専門医はその症例を組織学的に調べ、主治医をはじめ多くの臨床医を含めた検討会(臨床病理検討会CPC)で多面的に検討され、次の患者様の治療に生かされています。
病理検査部門の概要
患者様が病院に来院されると、適切な治療のために適切な診断が必要になります。「病理診断」は最終診断として大きな役割を果たしています。病理検査室では大きく分けて組織診断、細胞診断、病理解剖の3つを行っています。
■組織診断
◆生検組織診断
胃、大腸の内視鏡検査で病変部より小さな組織を採取し、その組織標本を作製し顕微鏡で診断します。
◆手術材料の診断
手術で切除した組織を標本にして顕微鏡でその病変の種類や進み具合を診断します。これをもとに手術後の治療が行われます。
◆術中迅速診断
手術中に切除範囲の決定や癌の転移の有無を調べる場合に行われます。手術中に採取された病変を凍結し、標本を作製、15分で病理診断が行われます。この診断結果をもとに手術方針が決定されます。
■標本の作製から診断まで
①ホルマリン固定
②切り出し:必要な部分を切り出す
③パラフィン包埋:パラフィンを浸透させ埋める
④薄切:薄く切る
⑤HE染色:色をつける
⑥顕微鏡でみて診断
■細胞診断
痰、尿、体腔液の中の細胞を集めたり、子宮の一部から細胞を擦り取って標本を作製しがん細胞を顕微鏡で調べます。また、乳腺や甲状腺のしこりは針で病変から吸引し、その細胞を診断します。

■病理解剖
不幸にしてなくなられた患者様を、ご遺族の承諾をもとに、ご遺体を解剖するのが病理解剖です。生前の診断が正しかったか、病気の進み具合、適切な治療がなされていたか、治療の効果はあったのか、死因は何かなどを検討します。 病理解剖が終わった後、病理専門医はその症例を組織学的に調べ、主治医をはじめ多くの臨床医を含めた検討会(臨床病理検討会CPC)で多面的に検討され、次の患者様の治療に生かされています。












